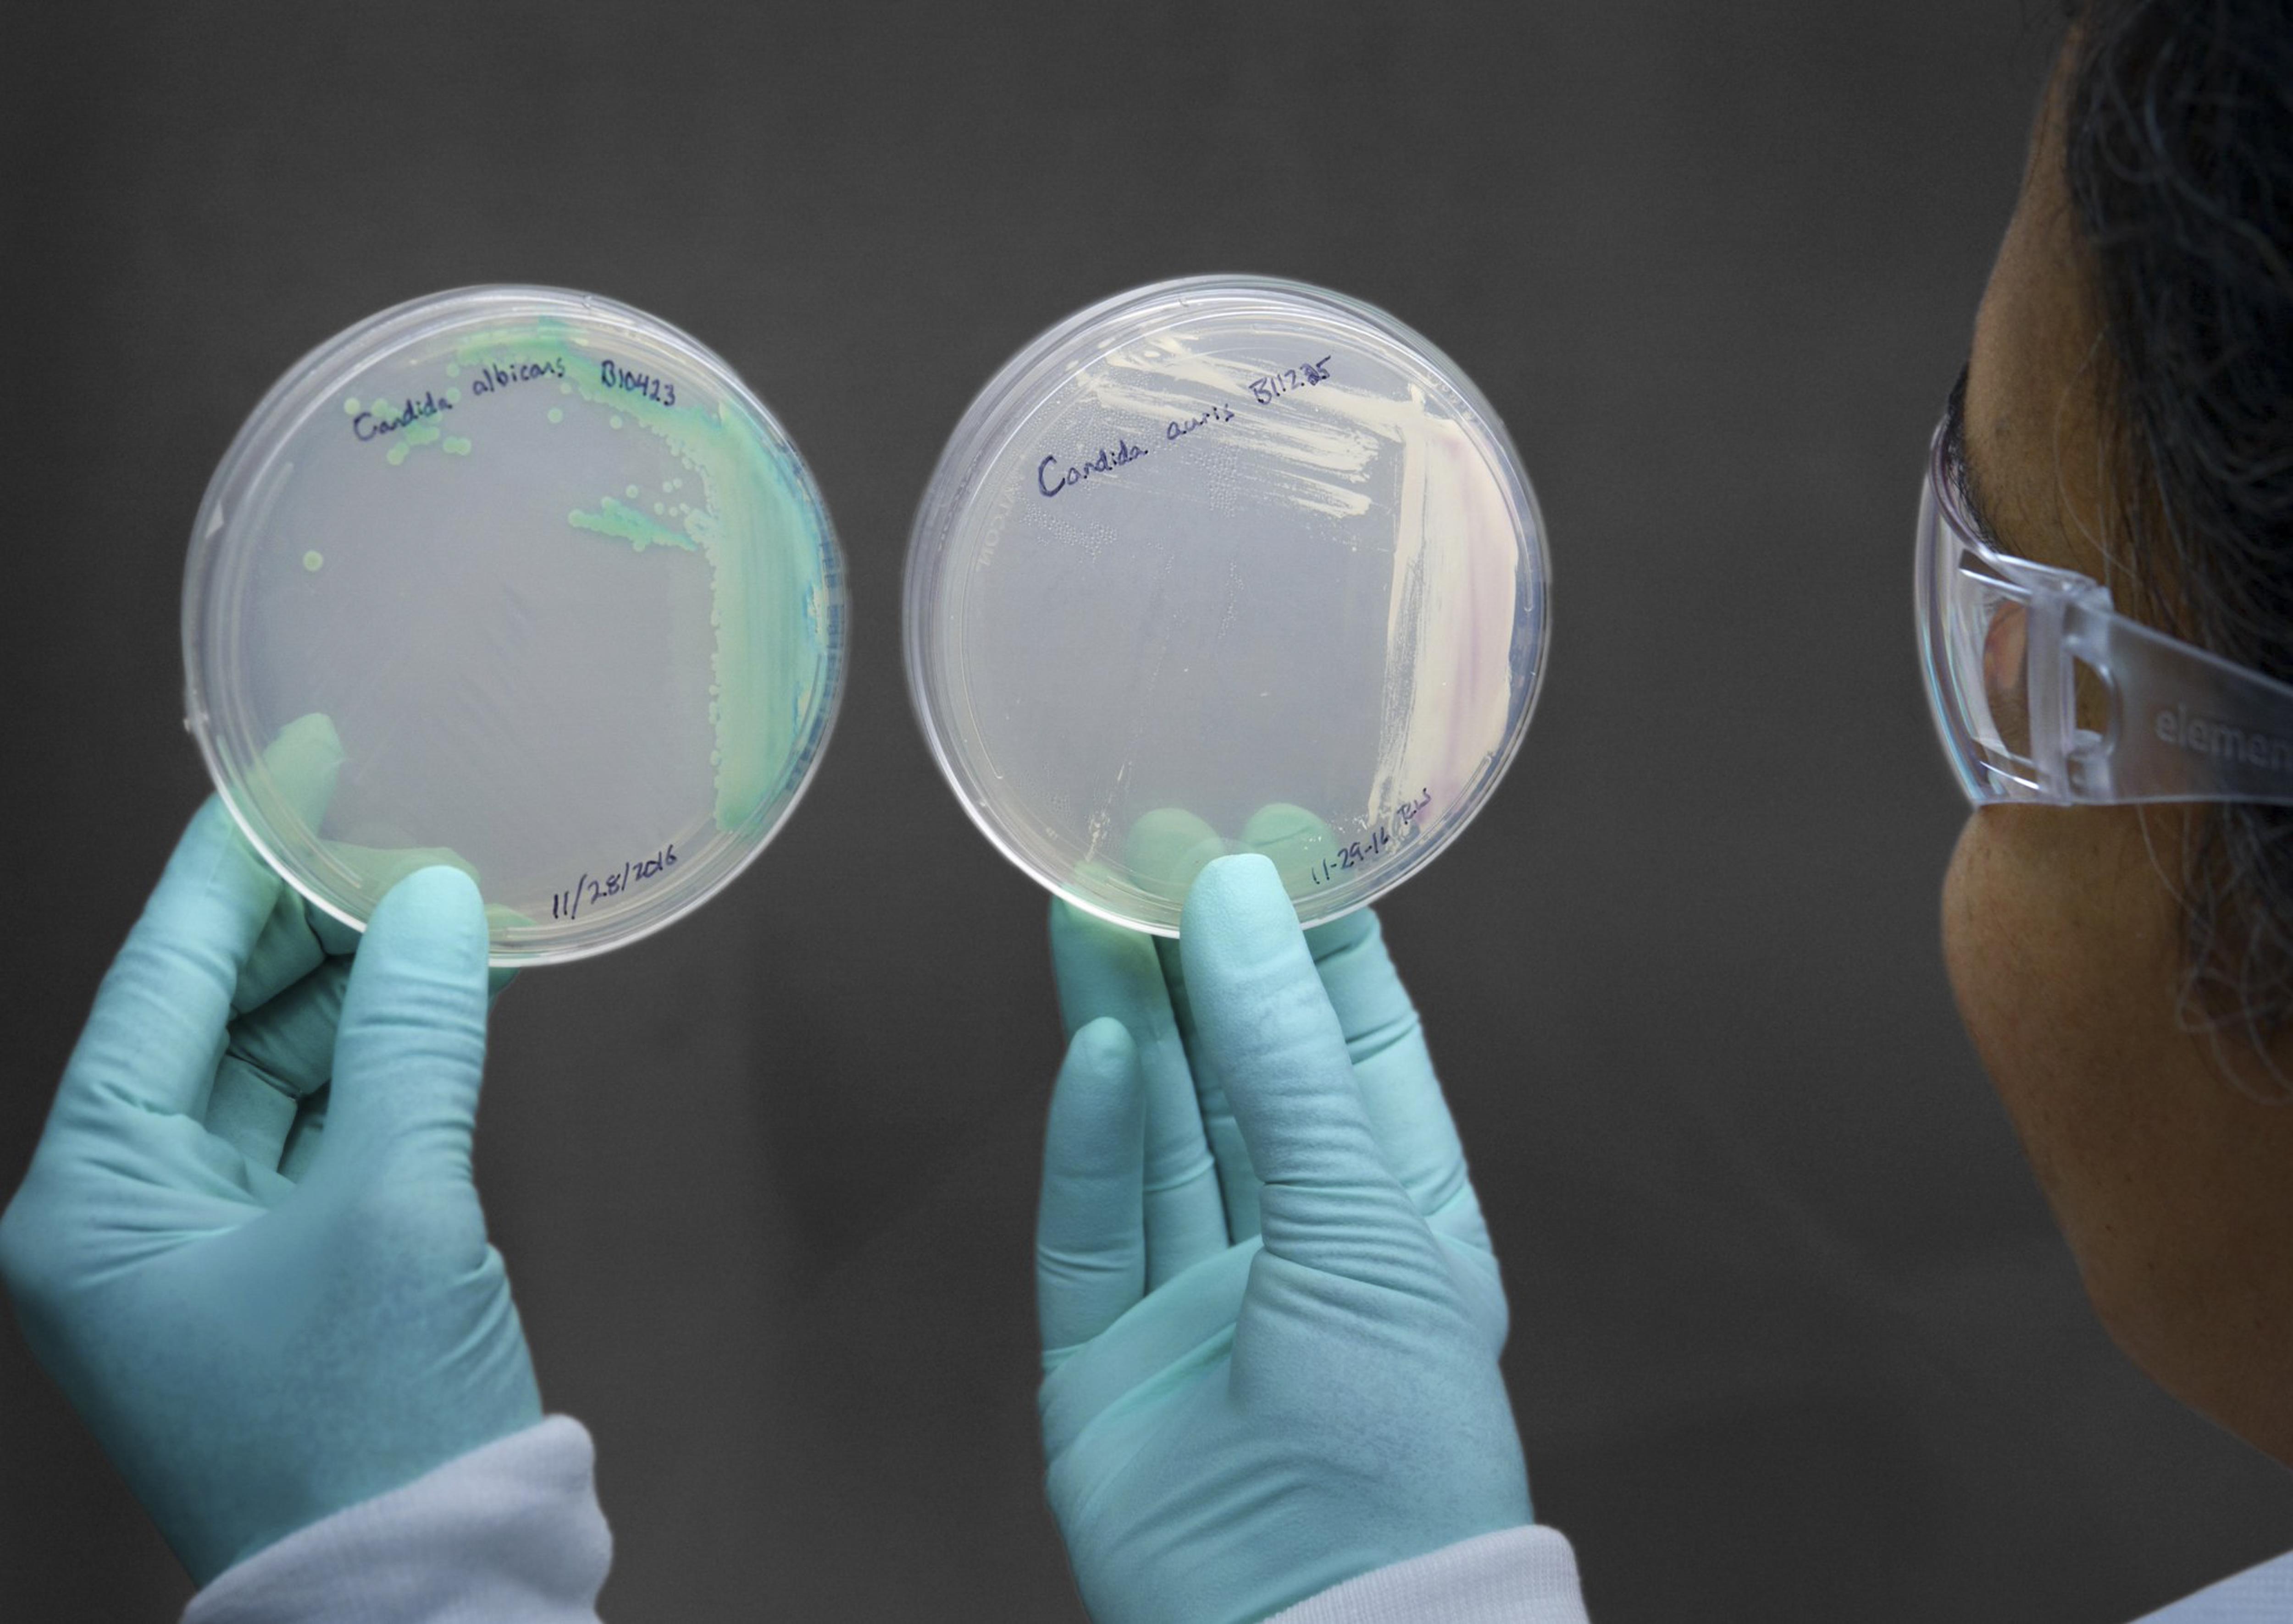

La OMS elabora una lista de los principales hongos que amenazan la salud Vanguardia.com.mx
10 de Mayo, 2025 14:37
10 de Mayo, 2025 14:37
Por: Andrew JacobsLa Organización Mundial de la Salud ha publicado una jerarquía de los hongos que han sido una amenaza para la salud del ser humano.
Es su iniciativa más ambiciosa para llamar la atención acerca de un conjunto de patógenos que con frecuencia han sido subestimados, aunque se propagan cada vez más y se han vuelto más letales y resistentes a los tratamientos.
Este organismo para la salud elaboró un listado de diecinueve enfermedades fúngicas invasoras, entre ellas cuatro que calificó como de “prioridad urgente”, que en su conjunto son las responsables de la muerte de 1,3 millones de personas y contribuyen al fallecimiento de cinco millones de personas cada año.
Muchos de esos decesos son de personas con VIH, cáncer, tuberculosis y otras enfermedades subyacentes que las dejan vulnerables a contraer infecciones.
Las autoridades sanitarias afirman que es probable que el número de muertos por infecciones fúngicas sea mucho más elevado debido a que muchos hospitales y clínicas, sobre todo en los países pobres, carecen de las herramientas de diagnóstico para identificarlas.
“El resultado es que las infecciones fúngicas invasoras se están volviendo más habituales, pero es frecuente que no se detecten ni se traten de manera adecuada”, señaló el martes en una conferencia de prensa Carmem L.
Pessoa da Silva, funcionaria de la OMS encargada de la vigilancia y el control de las enfermedades.
“No tenemos la verdadera noción de la magnitud del problema”.
La OMS elaboró un informe para hacer un llamado a la acción y los funcionarios mencionaron que esperaban que este ayudara a generar una mayor conciencia sobre esta urgencia entre los gobiernos, los fabricantes de medicamentos, los médicos y los especialistas en políticas sanitarias.
De acuerdo con la OMS, el cambio climático ha ayudado a que aumente el alcance geográfico y la incidencia de algunas infecciones.
La pandemia del coronavirus también ha dado lugar a un repunte de infecciones fúngicas entre los pacientes de COVID que terminan en las unidades de cuidados intensivos, donde algunas veces se desarrollan patógenos persistentes, como la Candida auris, que posteriormente invaden el cuerpo a través de las sondas para respirar y los catéteres intravenosos.
En estos últimos años, los medicamentos antimicóticos han estado perdiendo su acción curativa, así como ocurre con las bacterias nocivas que se desarrollan y se vuelven resistentes a los antibióticos debido al uso excesivo de estos, tanto en las personas como en la agricultura.
Los científicos han afirmado que los índices de resistencia cada vez mayores del Aspergillus fumigatus, un hongo común que puede ser fatal para quienes tienen un sistema inmunitario debilitado, han sido asociados al uso desmedido de fungicidas sobre cultivos comerciales como las uvas, el maíz y el algodón.
Cuando una infección fúngica entra en el torrente sanguíneo, el tratamiento se vuelve exponencialmente más difícil: por ejemplo, la mortalidad de las infecciones del torrente sanguíneo causadas por hongos pertenecientes a la familia candida es del 30 por ciento.
Esa cifra es considerablemente más elevada en los pacientes con Candida auris, uno de los cuatro hongos de “prioridad urgente” citados en el informe de la OMS.
Este hongo, una levadura identificada en Japón en 2009, se ha propagado a cuatro docenas de países y por lo general es resistente a más de un medicamento.
Solo hay cuatro tipos de fármacos para tratar las infecciones fúngicas, “y hay muy pocos nuevos en proceso”, señaló Hatim Sati, otro funcionario de la OMS que colaboró en la elaboración del informe y explicó que muchos de los medicamentos existentes son tan tóxicos que no es seguro que los tomen ciertos pacientes.
Los médicos y los investigadores señalaron que la decisión de la OMS los motivó a enfocar la atención en las infecciones fúngicas.
“Esto estaba pendiente desde hace mucho tiempo debido a que, también desde hace mucho, las enfermedades micóticas han sido subestimadas aun cuando el problema aumenta a una velocidad exponencial”, comentó Cornelius Clancy, médico especialista en enfermedades infecciosas en el Sistema de Atención Médica para Veteranos de Pittsburgh quien no colaboró en el informe.
David Denning, director general del Fondo de Acción Global para Infecciones Fúngicas, un grupo de apoyo, mencionó que, en cierta manera, el mal seguimiento era la causa de esa desatención.
Denning señaló que la incapacidad de diagnosticar las infecciones fúngicas implica que, a menudo, los pacientes no reciban tratamiento y citó las investigaciones en Kenia que revelaron que un mejor trabajo de seguimiento de la meningitis micótica habría salvado a 5000 pacientes con VIH al año.
También mencionó que las pruebas generalizadas tendrían un costo de cerca de 50.
000 dólares al año.
Según Denning, la falta de diagnóstico tiene otras consecuencias inadvertidas y nos dio el ejemplo hipotético de un paciente con leucemia que desarrolla alguna infección fúngica que resulta ser fatal.
“Si esa persona fallece de una infección fúngica, sus familiares van a querer donar dinero a alguna organización benéfica para la leucemia”, comentó.
“No lo van a donar a ninguna beneficencia para enfermedades micóticas porque lo que sabían estaba relacionado con la leucemia”.
